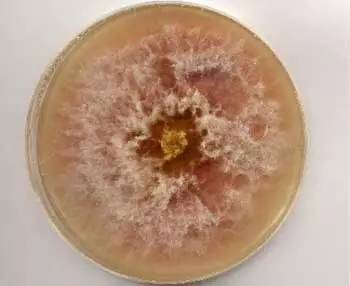
广西人警惕这种零食为一级致癌物,南宁人注意这些水果千万别买

做为一个24K的纯吃货,小南南除了告诉大家哪些东西好吃,哪些能吃,还会告诉大家哪些不能吃。就比如,小南南从广西食药局的官网上看到了这个信息,马上就来通知大家了。
小南南看到的是这个:
《广西壮族自治区食品药品监督管理局关于公布2015年执行国家食品药品监督管理总局食品安全监督抽检情况的公告(第28期)》

一口气读完,南哥差点一口气没接上来!但这都不是重点,重点是里面公布了不合格的产品都有哪些,其中有一部分在南宁的某些知名大超市也有卖的哦。小南南这就给大家列出来。
赶紧回家告诉爸妈,这些食品千万不要吃,因为食药局说它们不合格!!!

乳制品
抽检项目
包括真菌毒素、食品添加剂、兽药残留、重金属等指标
共抽检17批次产品,不合格3批次。抽检不合格的有:
1.广西百色壮牛牧业公司生产的“壮氏”水牛奶
规格型号:250ml/盒
生产日期/批号:2015-07-08
不合格项目:蛋白质、非脂乳固体
被抽样单位名称:田阳县阳光缘奶吧
2.广西百色壮牛牧业公司生产的“壮氏”AD水牛奶
规格型号:200ml
生产日期/批号:2015-11-22
不合格项目:大肠菌群
被抽样单位名称:广西百色壮牛牧业有限公司
3.广西百色壮牛牧业公司生产的“壮氏”鲜水牛奶
规格型号:200ml/瓶
生产日期/批号:2015-11-24
不合格项目:大肠菌群
被抽样单位名称:广西壮氏科技有限公司(南宁市秀灵路)
粮食及粮食制品

抽检项目
包括重金属、食品添加剂、微生物等指标
共抽检86批次,不合格产品5批次。抽检不合格的有:
1.贵港市海良商贸公司生产的“家家圣”食用生粉
规格型号:80g/包
生产日期/批号:2015-09-02
不合格项目:霉菌计数
被抽样单位名称:灵山县灵城镇肖丽平价商场
2.广州明誉食品发展有限公司生产的“仟润”马铃薯淀粉(土豆生粉)
规格型号:208g/包
生产日期/批号:2015-09-16
不合格项目:酵母和霉菌计数
被抽样单位名称:沃尔玛深国投百货有限公司南宁朝阳路分店
3.吉林省杞参食品有限公司生产的东北高粘淀粉(玉米淀粉)
规格型号:425g/包
生产日期/批号:2015-10-05
不合格项目:大肠菌群、霉菌计数
被抽样单位名称:沃尔玛深国投百货有限公司南宁朝阳路分店
4.山东成武县鸿昌粉条厂生产的“宝粒来”红薯粉丝
规格型号:400g/袋
生产日期/批号:2015-09-02
不合格项目:二氧化硫残留量
被抽样单位名称:沃尔玛深国投百货有限公司南宁朝阳路分店
5.中山市华联食品有限公司生产的“农家御品”新竹米粉
规格型号:750g/袋
生产日期/批号:2015-10-25
焙烤食品

抽检项目
包括重金属、微生物、食品添加剂等指标
共抽检91批次产品,不合格产品22批次。抽检不合格的有:
1.金城江四知堂健民食品厂生产的“四知堂”芝麻通心酥(饼干)
规格型号:140g
生产日期/批号:2015-08-06
不合格项目:二氧化硫(以二氧化硫残留量计)
被抽样单位名称:柳州市柳北区冠元食品饮料经营部
2.桂林茂信食品有限公司生产的“茂信”桂花米饼
规格型号:360克/袋
生产日期/批号:2015-05-05
不合格项目:过氧化值(以脂肪计)
被抽样单位名称:柳州市高新区金易达百货商场
3.桂林茂信食品有限公司生产的“茂信”香芋米饼
4.广西览众山食品有限公司生产的“览众山”桂花糕
规格型号:168克/包
生产日期/批号:2015-09-08
不合格项目:柠檬黄及其铝色淀(以柠檬黄计)
被抽样单位名称:广西联华超市股份有限公司柳州天和店
5.金城江四知堂健民食品厂生产的“四知堂”芝麻通心酥(饼干)
规格型号:30g/袋
生产日期/批号:2015-08-14
不合格项目:二氧化硫(以二氧化硫残留量计)
被抽样单位名称:柳州市燕芳小食品销售部
6.南宁市福财食品有限公司生产的东北小酥饼
规格型号:118克
生产日期/批号:2015-08-20
不合格项目:霉菌
被抽样单位名称:百色市右江区金福百货批零店
7.百色市右江区沁园食品厂生产的草莓乳酪面包
规格型号:60克
生产日期/批号:2015-10-18
不合格项目:糖精钠(以糖精计)
被抽样单位名称:百色市右江区金福百货批零店
8.百色市右江区沁园食品厂生产的相思豆面包
规格型号:100g
生产日期/批号:2015-10-15
不合格项目:糖精钠(以糖精计)、菌落总数
被抽样单位名称:百色市右江区金福百货批零店
9.百色市右江区旺兴佳食品厂生产的绿豆饼
规格型号:300克
生产日期/批号:2015-10-13
不合格项目:脱氢乙酸及其钠盐(以脱氢乙酸计)
被抽样单位名称:百色市右江区金福百货批零店
10.桂林桂品隆商贸有限公司生产的“桂隆”桂花酥
规格型号:200克/盒
生产日期/批号:2015-08-01
不合格项目:大肠菌群
被抽样单位名称:龙胜站前百货购物中心
11.桂林市铭园食品有限责任公司生产的“洺沅”桂花夹心米饼
规格型号:260g/袋
生产日期/批号:2015-09-03
不合格项目:糖精钠(以糖精计)、菌落总数
被抽样单位名称:桂林百货大楼股份有限公司王城商厦
12.桂林市晟盈食品有限责任公司生产的“晟盈”龙须酥(夹心绿茶味)
规格型号:200克/盒
生产日期/批号:2015-07-05
不合格项目:菌落总数
被抽样单位名称:桂林市七星区申苏莲糖烟酒店
13.桂林兰雨食品有限公司生产的“米啰”脆皮板栗糕
规格型号:200克/盒
生产日期/批号:2015-07-15
不合格项目:霉菌
被抽样单位名称:阳朔县大西街购物广场分店
14.桂林茂信食品有限公司生产的“茂信”黑芝麻糕
规格型号:150克/盒
生产日期/批号:2015-10-05
不合格项目:苋菜红及其铝色淀(以苋菜红计)、柠檬黄及其铝色淀(以柠檬黄计)、亮蓝及其铝色淀(以亮蓝计)、日落黄及其铝色淀(以日落黄计)
被抽样单位名称:恭城县恭城镇云松自选商场
15.广西桂平市思香圆食品厂生产的绿豆饼
规格型号:250克
生产日期/批号:2015-07-30
不合格项目:柠檬黄及其铝色淀(以柠檬黄计)
被抽样单位名称:田阳县冠超市商贸有限公司
16.平乐县嘉佳食品厂生产的萨琪玛(油炸类)
规格型号:225g/包
生产日期/批号:2015-10-05
不合格项目:菌落总数、大肠菌群
被抽样单位名称:恭城县恭城镇弘盛食杂店
17.桂林市六顺食品有限公司生产的“金隆园”芒果酥
规格型号:218克/盒
生产日期/批号:2015-05-28
不合格项目:铝的残留量(以干基计)
被抽样单位名称:凭祥市惠宜百汇购物中心
18.合浦县冠香食品厂生产的绿豆饼
规格型号:160克
生产日期/批号:2015-10-30
不合格项目:脱氢乙酸及其钠盐(以脱氢乙酸计)
被抽样单位名称:北海市海城区红林糖饼经营部
19.金城江四知堂健民食品厂生产的“四知堂”椰汁克力架(饼干)
规格型号:240g
生产日期/批号:2015-09-09
不合格项目:二氧化硫(以二氧化硫残留量计)
被抽样单位名称:钦州市钦南区文乐副食经营部
20.贺州市八步区汇味轩食品厂生产的吐司肉松面包
规格型号:90克
生产日期/批号:2015-10-20
不合格项目:菌落总数
被抽样单位名称:北海市海城区海景源超市
21.南宁大红桔食品有限责任公司生产的“壮乡人”大红桔夹心面包(香芋味)
规格型号:90克
生产日期/批号:2015-10-19
22.小叶香食品厂生产的面包
规格型号:80g
生产日期/批号:2015-09-06
不合格项目:大肠菌群
被抽样单位名称:玉林市小叶香食品有限公司
广西食药局的官网上说了,这些在抽检中发现的陋嘢食品,已经被责令下架、召回,同时要求企业查找问题原因并整改。如果你家里也买了上面这些食品,赶紧回家告诉爸妈和孩子,吃之前一定要看清楚,不要吃到了不合格的食品。

为什么这些食品不合格?
1菌落总数

菌落总数是指示性微生物指标,并非致病菌指标。主要用来评价食品清洁度,反映食品在生产过程中是否符合卫生要求。
菌落总数超标说明个别企业可能未按要求严格控制生产加工过程的卫生条件,或者包装容器清洗消毒不到位;还有可能与产品包装密封不严,储运条件控制不当等有关。
2大肠菌群

大肠菌群是国内外通用的食品污染常用指示菌之一。食品中检出大肠菌群,提示被致病菌(如沙门氏菌、志贺氏菌、致病性大肠杆菌)污染的可能性较大。本次检出大肠菌群超标的样品均未检出致病菌,结合居民膳食结构、抽检情况等因素综合分析,健康风险较低,但反映该食品卫生状况不达标。
本次监督抽检发现部分乳制品、粮食制品和焙烤食品存在大肠菌群超标的情况,原因可能由于产品的加工原料、包装材料受污染,或在生产过程中产品受人员、工器具等生产设备、环境的污染,或有灭菌工艺的产品灭菌不彻底而导致。
3甜味剂、防腐剂和食用色素

糖精钠为具有增加产品甜味作用的食品添加剂;脱氢乙酸为具有防腐作用的食品添加剂;柠檬黄、日落黄、苋菜红、亮蓝为具有赋予色泽和改善色泽作用的食品添加剂。根据食品安全国家标准和相关产品标准的规定,不允许超范围或超限量使用添加剂。
本次监督抽检发现3批次焙烤食品食品存在超范围使用甜味剂(主要是糖精钠等)的情况。原因可能是企业为增加产品甜味而超范围使用。
本次监督抽检发现2批次焙烤食品存在超限量使用防腐剂(主要是脱氢乙酸等)的情况。原因可能是企业为增加产品保质期,或者弥补产品生产过程卫生条件不佳而超限量使用,或者未准确计量。
本次监督抽检发现2批次焙烤食品存在超范围使用食用色素(主要是柠檬黄、日落黄、苋菜红、亮蓝等)的情况。原因可能是由于企业为增加产品卖相,或者弥补原料品质较低而超范围添加食用色素。
4二氧化硫

二氧化硫是食品加工中常用的漂白剂和防腐剂,进入人体内后最终转化为硫酸盐并随尿液排出体外。若过量食用会引起如恶心、呕吐等胃肠道反应。
本次监督抽检发现3批次焙烤食品存在超限量使用二氧化硫情况,2批次粮食制品存在超限量使用二氧化硫情况。原因可能是个别生产者使用劣质原料以降低成本,其后为了提高产品色泽超量使用二氧化硫;也有可能是防止霉变生虫,违规对其进行二氧化硫熏蒸或添加。
4霉菌和酵母
本次监督抽检发现3批次焙烤食品和2批次粮食及粮食制品霉菌超标主要原因可能是原料或包装材料受到霉菌污染,产品在生产加工过程中卫生条件控制不到位,生产工器具等设备设施清洗消毒不到位或产品储运条件不当而导致。
霉菌和酵母在自然界很常见,可使食品腐败变质,破坏食品的色、香、味,降低食品的食用价值,本次抽检共发现1批次粮食与粮食制品霉菌和酵母超标,霉菌和酵母超标原因可能是加工用原料受污染或产品储运条件控制不当所致。超标产品未检出真菌毒素、致病菌。
6过氧化值

过氧化值主要反映油脂是否氧化变质。随着油脂氧化,过氧化值会逐步升高,虽一般不会对人体的健康产生损害,但严重时会导致肠胃不适、腹泻等症状。
本次抽检共发现2批次焙烤食品过氧化值超标,超标的原因可能是产品用油已经变质,或者产品在储存过程中环境条件控制不当,导致油脂酸败;也可能是原料中的脂肪已经氧化,原料储存不当,未采取有效的抗氧化措施,使得最终产品油脂氧化。
7蛋白质

蛋白质、非脂乳固体是反映乳制品质量的重要指标。这两个项目不达标,说明企业生产加工过程中可能存在偷工减料、以次充好的情况。
8铝残留量

含铝食品添加剂(比如明矾)是合法的食品添加剂,按标准使用不会对健康造成危害。根据国家食品安全风险评估专家委员会完成的中国居民膳食铝暴露风险评估结果,我国日常膳食中的含铝食品对一般居民健康造成不良影响的可能性不大,但对于长期食用高铝食品的消费者应予以关注。
铝残留量超标的原因可能是企业为增加产品口感,在生产加工过程中超限量使用含铝添加剂,或者其使用的复配添加剂中铝含量过高。